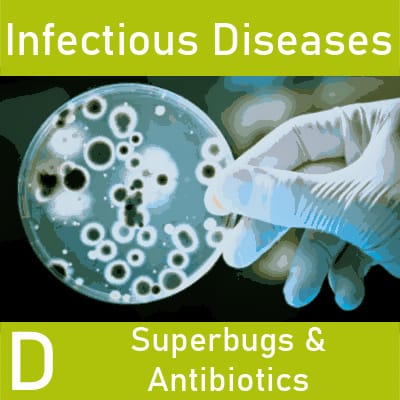
Infectious Diseases Update D: Healthcare Acquired Infections, STBB, & Antibiotic Stewardship

Description
Duration:
120 minutes including a Q&A
Includes:
• The on-demand recording to watch later at your convenience
• A handout in PDF format for viewing or self-printing
• A certificate of completion
Topics:
• The problem of Healthcare Associated Infections
• How high is the incidence of hospital acquired infections?
• Superbugs and the threat to patient safety – is anything helping to slow them down?
• Aspergillus baumanii, Candida auris, and Clostridiodes difficile
• MRSA, VRE and CRE – who is at risk?
• What are the two rules of Antibiotic stewardship?
• What is optimal duration of antibiotics for common infections like acute cystitis and community acquired pneumonia?
• Other ways to reduce the overuse and abuse of antibiotics
Description:
Few areas in healthcare are changing as rapidly as infectious diseases. This four part webinar provides an up-to-the minute update on current issues in infectious diseases. Major infectious disease trends will be reviewed, including: COVID-19, impact of global warming, food-borne illnesses, infectious agents and their relationship to acute and chronic disease. New vaccines, like for COVID-19, HPV and other diseases, will be reviewed, along with the status of older vaccines. Superbugs, healthcare acquired infections and antibiotic stewardship will also be discussed. Join us for this very timely topic!
Who Should Attend?:
• RNs, NPs, RPNs, & LPNs in public health, acute, community, primary & long term care settings
• Infection Control Practitioners, Occupational Health Nurses;
• Physician Assistants, Dietitians, Chiropractors, Pharmacy Technicians
• Nurse Practitioners, Tele-Health Nurses, Educators, Managers
Barb Bancroft, RN, MSN, PNP
Barb Bancroft is a widely acclaimed nursing teacher who has taught courses on Advanced Pathophysiology, Pharmacology, and Physical Assessment to both graduate and undergraduate students. Also certified as a Pediatric Nurse Practitioner, she has held faculty positions at the University of Virginia, the University of Arkansas, Loyola University of Chicago, and St. Xavier University of Chicago. Barb is known for her extensive knowledge of pathophysiology and as one of the most dynamic nursing speakers in North America today. Delivering her material with equal parts of evidence based practise, practical application, and humour, she has taught numerous seminars on clinical and health maintenance topics to healthcare professionals, including the Association for Practitioners for Infection Control, The Emergency Nurses’ Association, the American Academy of Nurse Practitioners, and more.